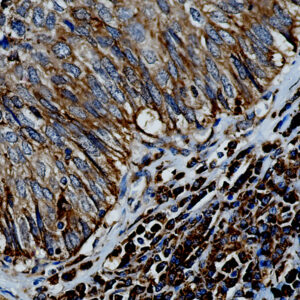
Anti-IL-15
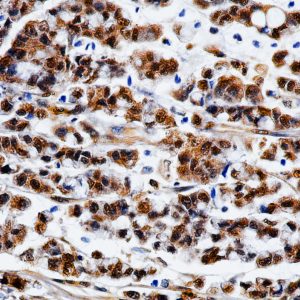
AMC98

Both
Showing 61–80 of 703 resultsSorted by latest
-

Anti-SATB2
Price range: $269.00 through $959.00 Select options This product has multiple variants. The options may be chosen on the product page -

Anti-MCM3
Price range: $269.00 through $1,149.00 Select options This product has multiple variants. The options may be chosen on the product page -

Anti-H.Pylori
Price range: $269.00 through $1,399.00 Select options This product has multiple variants. The options may be chosen on the product page -

Anti- SOX-11
Price range: $269.00 through $1,235.00 Select options This product has multiple variants. The options may be chosen on the product page -

PARP-1
Price range: $269.00 through $1,235.00 Select options This product has multiple variants. The options may be chosen on the product page -

Anti- TMPRSS2
Price range: $269.00 through $1,149.00 Select options This product has multiple variants. The options may be chosen on the product page -

Anti-Somatostatin
Price range: $269.00 through $1,235.00 Select options This product has multiple variants. The options may be chosen on the product page -

Anti-PIT-1
Price range: $269.00 through $1,235.00 Select options This product has multiple variants. The options may be chosen on the product page -

Anti- IL-5
Price range: $269.00 through $1,180.00 Select options This product has multiple variants. The options may be chosen on the product page -

Anti-ALDH1A1
Price range: $269.00 through $1,265.00 Select options This product has multiple variants. The options may be chosen on the product page -

Anti-Progesterone Receptor
Price range: $269.00 through $1,430.00 Select options This product has multiple variants. The options may be chosen on the product page -

Anti-SFTPD
Price range: $269.00 through $1,265.00 Select options This product has multiple variants. The options may be chosen on the product page -

Anti-IL-6ST
Price range: $269.00 through $1,265.00 Select options This product has multiple variants. The options may be chosen on the product page -

Anti-MTAP
Price range: $250.00 through $1,265.00 Select options This product has multiple variants. The options may be chosen on the product page -

Anti-Steroidogenic Factor (SF1)
Price range: $269.00 through $1,185.00 Select options This product has multiple variants. The options may be chosen on the product page -

Anti-TTF-1
Price range: $250.00 through $1,112.00 Select options This product has multiple variants. The options may be chosen on the product page -

Anti-HHV-8
Price range: $250.00 through $1,235.00 Select options This product has multiple variants. The options may be chosen on the product page -

Anti- PAX2
Price range: $269.00 through $1,430.00 Select options This product has multiple variants. The options may be chosen on the product page -
Anti-IL-15
Price range: $269.00 through $1,289.00 Select options This product has multiple variants. The options may be chosen on the product page -
Anti-IL-3
Price range: $269.00 through $1,289.00 Select options This product has multiple variants. The options may be chosen on the product page

